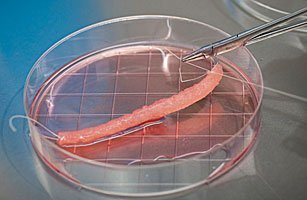

Dự báo trước cái chết bằng xét nghiệm máu là một trong 10 đột phá y học đáng chú nhất trong năm 2011 theo bình chọn của Tạp chí Time.
Tin liên quan:
Bi kịch thiếu nữ cứ tắm là bất động
Mẹ 240 kg sinh con nặng gần 7 kg
Xét nghiệm mới giúp phát hiện sớm bệnh ung thư
1. Tạo tế bào gốc bằng phương pháp nhân bản vô tính

Đây không hoàn toàn là nhân nhân bản vô tính người, nhưng cũng gần như vậy. Các nhà khoa học thuộc Tổ chức nghiên cứu tế bào gốc New York (Mỹ) đã sử dụng kỹ thuật chuyển nhân tế bào xôma (SCNT) - kỹ thuật từng được sử dụng để tạo ra cừu Dolly vô tính - trên tế bào cơ thể người.
Kỹ thuật SCNT bao gồm việc thay thế vật chất di truyền của một tế bào trứng bằng ADN từ tế bào trưởng thành (ví dụ tế bào da). Trứng sau đó được kích thích để phân chia và nếu phát triển đầy đủ, quá trình này sẽ tạo ra một động vật vô tính giống với động vật cung cấp tế bào trưởng thành.
Tuy nhiên, nhóm các nhà khoa học Mỹ đã biến đổi kỹ thuật SCNT, bằng cách kết hợp ADN của tế bào người trưởng thành với vật chất di truyền của một trứng thay vì loại bỏ ADN của trứng. Sự kết hợp này tạo thuận lợi cho quá trình phân chia tế bào và cho phép sinh ra tế bào gốc.
Trong tương lai, quy trình trên rất có triển vọng vì có thể sinh ra tế bào gốc - áp dụng trong điều trị nhiều bệnh như tổn thương đốt sống hay Parkinson's.
2. Vắc-xin phòng chống bệnh sốt rét

Vắc-xin phòng chống sốt rét đầu tiên RTS,S đã được thử nghiệm trên trẻ ở khu vực châu Phi hạ Sahara. Kết quả thử nghiệm cho thấy, trẻ được tiêm RTS,S có nguy cơ mắc sốt rét thấp hơn 50% so với trẻ không tiêm. Ngoài ra, số ca mắc bệnh sốt rét nặng ở nhóm trẻ em được tiêm vắc-xin RTS,S cũng giảm 47%.
Quá trình thử nghiệm vẫn chưa kết thúc, các nhà khoa học sẽ tiếp tục tiến hành theo dõi 15.460 trẻ em được tiêm RTS,S để xem vắc-xin này có tác dụng phòng chống lâu dài không. Các nhà khoa học hy vọng loạt vắc-xin phòng sốt rét đầu tiên sẽ chính thức được sản xuất vào năm 2014.
3. Thuốc phòng ngừa HIV

Điều trị bệnh HIV đã đi được một chặng đường dài nhờ thuốc ARV - có thể giúp giảm lượng virút trong cơ thể và giảm nguy cơ lây nhiễm virút HIV. Trong năm 2011, các nhà khoa học tiếp tục đạt những bước tiến trong việc phát triển các loại thuốc mới điều trị bệnh HIV hiệu quả hơn.
Nghiên cứu đầu tiên được các nhà khoa học thuộc Đại học Washington (Mỹ) thử nghiệm trên 4.758 cặp đôi không đồng tính. Một người trong mỗi cặp đôi bị HIV dương tính, người còn lại không nhiễm. Một số trong nhóm này được cho uống thuốc Truvada, con lại uống giả dược. Kết quả, những người uống Truvada thường xuyên giảm 73% nguy cơ lây nhiễm HIV từ bạn tình.
Một nghiên cứu khác của các nhà khoa học thuộc Trung tâm phòng chống dịch bệnh Mỹ được tiến hành với 1.200 đàn ông và phụ nữ khỏe mạnh. Những người này cũng được yêu cầu uống thuốc Truvada và kết quả giúp họ giảm 63% nguy cơ lây nhiễm HIV.
4. Thay đổi quan trọng trong tháp dinh dưỡng

Cứ 5 năm một lần, chính phủ Mỹ lại tiến hành cập nhật Hướng dẫn chế độ ăn uống cho người dân nước này (DGA). Trong bản cập nhật năm nay, các chuyên gia dinh dưỡng khuyến cáo người dân giảm ăn thực phẩm như đường, muối và chất béo, đồng thời ăn nhiều những loại thực thẩm gốc thực vật và đồ biển, cũng như tập luyện thể dục thường xuyên khoảng 150 phút/tuần đối với người trưởng thành.
Đến tháng 6/2011, chính phủ Mỹ đưa ra một bản đồ thực phẩm mới có tên là MyPlate - dựa trên các khuyến cáo của DGA. Bản đồ dinh dưỡng này có hình đĩa thay vì hình kim tự tháp như truyền thống.
Thực phẩm trên đĩa được chia thành 4 nhóm, bao gồm: trái cây, rau, ngũ cốc và protein. Khoảng một nửa số thực phẩm trong cái đĩa này gồm rau quả, ngũ cốc và chỉ một phần nhỏ gồm thịt và sữa. Các chuyên gia sức khỏe hy vọng biểu đồ mới sẽ giúp người dân lựa chọn thực phẩm theo hướng có lợi hơn cho sức khoẻ, điều mà mô hình kim tự tháp đã không làm được.
5. Nuôi cấy bộ phận cơ thể người trong phòng thí nghiệm
Tiến sĩ Anthony Atala, giám đốc Viện nghiên cứu Thuốc tái sinh Wake Forest (Mỹ), và các cộng sự đã nuôi cấy thành công ống niệu đạo của cơ thể người trong phòng thí nghiệm vào tháng 3 vừa qua.
Atala đã tạo ra một mô hình đoạn ống niện đạo bị tổn thương cần thay thế. Sau đó, cấy các tế bào bàng quang của bệnh nhân lên mô hình ống niệu đạo trong phòng thí nghiệm. Ống niệu đạo được nuôi cấy thành công được ghép trở lại vào cơ thể bệnh nhân và nó làm việc khá hoàn hảo.
Phương pháp này mở ra hy vọng thay thế các bộ phận khác trong cơ thể theo kỹ thuật tương tự.
6. Mối liên hệ bí hiểm giữa vi khuẩn và bệnh ung thư ruột kết

Bệnh ung thư ruột kết có phải do vi khuẩn gây ra? Vào tháng 10/2011, hai nhóm nghiên cứu đã cho ra kết quả tương tự nhau khi phát hiện một loại vi khuẩn mang tên Fusobacteria - rất hiếm khi phát hiện trong ruột của chúng ta, nhưng dường như lại tập trung rất đông trong những vùng cơ thể có chứa tế bào ung thư ruột kết.
So sánh những tế bào ruột kết khỏe mạnh và những tế bào ung thư, các nhà khoa học nhận thấy Fusobacteria tập trung ở các tế bào ung thư ruột kết gấp hàng trăm lần so với số lượng Fusobacteria tập trung ở các tế bào ruột kết khỏe mạnh. Đáng chú ý, đây là lần đầu tiên vi khuẩn Fusobacteria được phát hiện liên quan tới bệnh ung thư.
7. 'Tiên dược' giúp giảm cân

Trong một nghiên cứu được công bố năm 2011, các nhà khoa học đã tạo ra một loại thuốc có tên là Qnexa. Nhóm nghiên cứu cho biết loại thuốc này có thể giúp những người béo phì giảm được 10% trọng lượng cơ thể trong vòng 1 năm.
Thuốc Qnexa là sự kết hợp của hai thuốc bao gồm, thuốc phentermine giảm béo và thuốc chống động kinh topiramate. Ý tưởng của các nhà khoa học là chống lại tình trạng béo phì trên hai cấp độ: phentermine có thể giúp giảm chứng thèm ăn, trong khi topiramate kiểm soát khả năng đốt calorie của cơ thể bằng cách điều khiển các liên lạc giữa các dây thần kinh trong não bộ.
Trong một nghiên cứu khác, các nhà khoa học thuộc Trung tâm nghiên cứu ung thư Anderson (Mỹ) thử nghiệm hợp chất adipotide - loại thuốc dựa trên nghiên cứu về ung thư, và thấy rằng thuốc này giúp những con khỉ béo phì giảm 11% trọng lượng cơ thể chỉ trong vòng 1 tháng.
8. Chó có thể phát hiện ung thư phổi

Theo nghiên cứu của các nhà khoa học người Đức, chó có thể phát hiện thấy một người mắc bệnh ung thư qua hơi thở.
Các nhà khoa học đã tiến hành thí nghiệm bằng cách huấn luyện những con chó trong vòng 9 tháng để phân biệt mùi hơi thở của những bệnh nhân bị ung thư phổi với những người khỏe mạnh. Kết quả thử nghiệm sau khi đào tạo cho thấy chúng có thể nhận diện chính xác 71/100 mẫu thử ung thư và lựa chọn các mẫu thử không chứa bệnh ung thư với tỉ lệ chính xác lên tới 93% .
9. Xác định tuổi bằng nước bọt

Mặc dù được trang bị rất nhiều công cụ hiện đại, nhưng kỹ thuật pháp y vẫn không thể xác định tuổi của một thi thể vào thời điểm tử vong. Trở ngại này đã tìm được lời giải nhờ công nghệ xét nghiệm nước bọt đơn giản.
Tháng 6/2011, các nhà khoa học thuộc Đại học California (Mỹ) cho biết đã tìm ra phương thức xác định độ tuổi của một thi thể, chỉ thông qua phân tích mẫu nước bọt.
Nhóm nghiên cứu thấy mẫu nước bọt của một người có chứa các yếu tố gen di truyền và những yếu tố này sẽ thay đổi trước các tác động của môi trường bên ngoài như cách ăn uống, sức ép, ánh sáng mặt trời và thậm chí cả chất độc. Tại một khu vực của bộ gen này có chứa một thành phần đóng vai trò như cột mốc đo thời gian, có thể cho biết độ tuổi của nạn nhân với sai số dao động trong khoảng 5 năm.
10. Dự báo trước cái chết bằng xét nghiệm máu

Các nhà khoa học thuộc trường đại học Uppsala (Thụy Điển) cho biết rằng một thử nghiệm máu thông thường có thể đoán được ai đó có thể chết vì ung thư hoặc bệnh tim. Trong nghiên cứu kéo dài 12 năm với gần 2000 bệnh nhân, các nhà khoa học nhận thấy những người có lượng enzim cathepsin S cao có nguy cơ tử vong cao hơn.
Loại enzym này cũng thường xuất hiện nhiều trong cơ thể những người có bệnh tim hoặc chứa khối u. Người béo phì cũng có nhiều enzim cathepsin S - không có gì đáng ngạc nhiên, bởi bởi béo phì là yếu tố quan trọng gây nên các căn bệnh liên quan tới tim mạch.
Hà Hương
|
5 loài động vật mới kỳ lạ nhất 2011
2011 tiếp tục ghi nhận nhiều loại động vật mới kỳ lạ, thậm chí quái dị.
Những nghiên cứu “ngớ ngẩn” nhất năm 2011
Tiền của, công sức, thời gian đã được rót cho những nghiên cứu chỉ để chứng minh điều không thể hiển nhiên hơn.
10 sự kiện vũ trụ lớn nhất năm 2011
Các chuyên gia Tạp chí TIME đã xếp hạng những sự kiện vũ trụ có ý nghĩa nhất trong năm 2011 vừa qua.
Ảnh vũ trụ đẹp nhất 2011
Tạp chí khoa học National Geographic vừa bình chọn những bức ảnh
vũ trụ đẹp nhất được đăng trên tạp chí này trong năm 2011.
|



